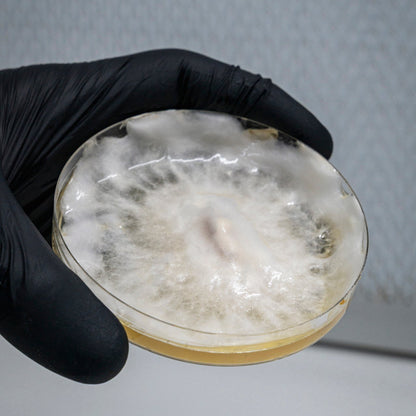
Mushroom Cultivation Workshop

1
/
of
4
MOGU Amsterdam
Mushroom Cultivation Workshop
Mushroom Cultivation Workshop
Regular price
€95,00
Regular price
€120,00
Sale price
€95,00
Taxes included.
Quantity
Couldn't load pickup availability
Learn to Grow Gourmet Mushrooms at Home.
No Experience Needed!
🌿 Discover the Magic of Mushrooms
Join us for a hands-on, one-day workshop designed to teach you the fundamentals of mushroom cultivation. Whether you're a complete beginner, a foodie, or an aspiring urban farmer, this course will give you the knowledge and confidence to start growing mushrooms at home.
🧠 What You’ll Learn:
 The mushroom life cycle – from spore to fruiting body
The mushroom life cycle – from spore to fruiting body
 How to create a clean and successful growing environment
How to create a clean and successful growing environment
 Different growing methods
Different growing methods
 Substrate preparation and pasteurization techniques
Substrate preparation and pasteurization techniques
 Inoculation and colonization steps
Inoculation and colonization steps
 Fruiting conditions and troubleshooting tips
Fruiting conditions and troubleshooting tips
 Harvesting and storing your mushrooms
Harvesting and storing your mushrooms
 Introduction to gourmet species: Lion’s Mane, Oyster, Shiitake & more
Introduction to gourmet species: Lion’s Mane, Oyster, Shiitake & more
🛠️ What’s Included:
 Your own Lion’s Mane or Oyster mushroom grow kit to take home
Your own Lion’s Mane or Oyster mushroom grow kit to take home
 All necessary materials, tools, and protective equipment for the workshop
All necessary materials, tools, and protective equipment for the workshop
 Coffee, tea, and snacks throughout the day
Coffee, tea, and snacks throughout the day
 Q&A time with a professional cultivator
Q&A time with a professional cultivator
👨 Taught by Experts
Our experienced instructors from MOGU's Mushroom Lab will guide you step by step through the process, sharing insider tips and real-world experience from running a working mushroom farm.
🎁 Bonus:
All participants receive a 10% discount on any future grow kits, spawn, or supplies ordered through our webshop!
📩 Reserve Your Spot Today!
Spaces are limited to ensure personal attention and hands-on experience. Book now and start your journey into the fascinating world of fungi.
Share




Subscribe to our emails
Be the first to know about new collections and exclusive offers.